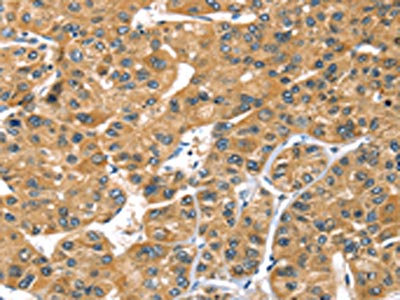

PRSS50 Antibody
-
中文名稱:PRSS50兔多克隆抗體
-
貨號:CSB-PA567041
-
規格:¥1100
-
圖片:
-
The image on the left is immunohistochemistry of paraffin-embedded Human liver cancer tissue using CSB-PA567041(PRSS50 Antibody) at dilution 1/30, on the right is treated with synthetic peptide. (Original magnification: ×200)
-
The image on the left is immunohistochemistry of paraffin-embedded Human esophagus cancer tissue using CSB-PA567041(PRSS50 Antibody) at dilution 1/30, on the right is treated with synthetic peptide. (Original magnification: ×200)
-
Gel: 8%SDS-PAGE, Lysate: 40 μg, Lane: Hepg2 cells, Primary antibody: CSB-PA567041(PRSS50 Antibody) at dilution 1/450, Secondary antibody: Goat anti rabbit IgG at 1/8000 dilution, Exposure time: 3 minutes
-
-
其他:
產品詳情
-
Uniprot No.:
-
基因名:PRSS50
-
別名:Cancer/testis antigen 20 antibody; CT 20 antibody; CT20 antibody; Probable threonine protease PRSS50 antibody; PRSS50 antibody; Serine protease 50 antibody; Testes specific protease 50 antibody; Testis specific protease like protein 50 antibody; Testis-specific protease-like protein 50 antibody; TSP 50 antibody; TSP50_HUMAN antibody
-
宿主:Rabbit
-
反應種屬:Human
-
免疫原:Synthetic peptide of Human PRSS50
-
免疫原種屬:Homo sapiens (Human)
-
標記方式:Non-conjugated
-
抗體亞型:IgG
-
純化方式:Antigen affinity purification
-
濃度:It differs from different batches. Please contact us to confirm it.
-
保存緩沖液:-20°C, pH7.4 PBS, 0.05% NaN3, 40% Glycerol
-
產品提供形式:Liquid
-
應用范圍:ELISA,WB,IHC
-
推薦稀釋比:
Application Recommended Dilution ELISA 1:2000-1:5000 WB 1:500-1:2000 IHC 1:25-1:100 -
Protocols:
-
儲存條件:Upon receipt, store at -20°C or -80°C. Avoid repeated freeze.
-
貨期:Basically, we can dispatch the products out in 1-3 working days after receiving your orders. Delivery time maybe differs from different purchasing way or location, please kindly consult your local distributors for specific delivery time.
-
用途:For Research Use Only. Not for use in diagnostic or therapeutic procedures.
相關產品
靶點詳情
-
功能:May be involved in proteolysis through its threonine endopeptidase activity.
-
基因功能參考文獻:
- TSP50 promotes the proliferation, migration and invasion of gastric cancer cells involving NF-kappaB dependent EMT activation. Targeting TSP50 may provide a novel therapeutic strategy for the management of gastric cancer PMID: 29361914
- human epidermal growth factor receptor 2 (HER-2) levels, were correlated well with TSP50/p-Samd2/3 and TSP50/p27 expression status. Thus, our studies revealed a novel regulatory mechanism underlying TSP50-induced cell proliferation and provided a new favorable intervention target for the treatment of breast cancer PMID: 28650473
- In patients with Colon cancer, the expression of TSP50 gene was associated with a poor prognosis. PMID: 28631709
- TSP50 plays a significant role in NSCLC cell proliferation and may act as a novel oncogene in the development and progression of NSCLC. PMID: 27109614
- Results suggest that 7P3A, which consists of 70 % 25-methoxyl-dammarane-3beta, 12beta, 20-triol and 30 % artemisinin, exhibits anti-cancer effects, in part, through downregulation of testes-specific protease 50 (TSP50) expression. PMID: 27039397
- Results show that TSP50 is up-regulated in laryngocarcinoma tumour tissues and its down-regulation inhibits cell proliferation, reduces cell migration and induces cell apoptosis of laryngocarcinoma in NF-KB mediated pathway. PMID: 25399078
- we found that some breast cancer diagnosis-associated features such as tumor size, tumor grade, estrogen receptors (ER) and progesterone receptors (PR) levels, were correlated well with TSP50/p65 and TSP50/MMP9 expression status PMID: 25811800
- TSP50's threonine protease activity is crucial for its effects on tumor formation. PMID: 25312478
- The mutations in the catalytic triad of TSP50 could significantly depressed TSP50-mediated cell proliferation and tumor formation. PMID: 25049081
- High TSP50 expression is associated with laryngocarcinoma. PMID: 25077921
- the importance of threonine 310, the most critical protease catalytic site in TSP50, to TSP50-induced cell proliferation and tumor formation PMID: 22574111
- TSP50 is a potential effective indicator of poor survival for colorectal carcinoma patients, especially for those with early-stage tumors. PMID: 21765952
- Results strongly suggest that bFGF mediates TSP50 downregulation by ERK1/2 activation, leading to the phosphorylation of Sp1 in this process. PMID: 20506264
- TSP50, a possible protease in human testes, is activated in breast cancer epithelial cells. PMID: 11782390
- TSP50 was largely downregulated in all testicular germ cell tumors. It may function in mammalian spermatogenesis. Its linear catalytic structure is similar to many serine proteases, except for a Thr-for-Ser residual catalytic site substitution. PMID: 15491742
- Overexpression of Sp1 and C/EBPbeta transcriptional factors upregulated the activities of the TSP50 promoter. PMID: 18462069
- These findings suggested that DNA methylation might regulate the TSP50 and mTSP50 gene expressions in different types of tissues and spermatic cells. PMID: 18662669
顯示更多
收起更多
-
亞細胞定位:Endoplasmic reticulum. Note=May also localize to cytoplasmic membranes.
-
蛋白家族:Peptidase S1 family
-
組織特異性:Testis specific. Differentially expressed in some breast cancer tissues.
-
數據庫鏈接:
Most popular with customers
-
-
YWHAB Recombinant Monoclonal Antibody
Applications: ELISA, WB, IHC, IF, FC
Species Reactivity: Human, Mouse, Rat
-
Phospho-YAP1 (S127) Recombinant Monoclonal Antibody
Applications: ELISA, WB, IHC
Species Reactivity: Human
-
-
-
-
-